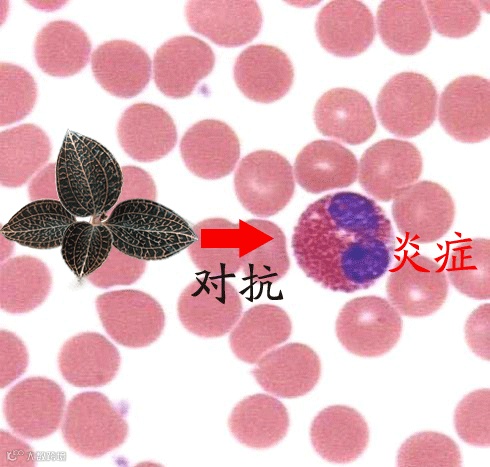

痰是人体呼吸道的分泌物,它是通过支气管纤毛运动上皮纤毛的运动,从肺部向上呼吸道推动,最后,通过人的正常咳嗽反射从气管内咳出排出体外,正常人痰很少,只是保持呼吸道湿润而分泌的少量粘液。
但当人吸入刺激性气体、尘埃、致病细菌、病毒等有害微生物时,上呼吸道就可能发生炎症,或者肺部发生疾病,呼吸道就会分泌增加,痰量就会增加,而痰的性质也会发生变化,由粘痰变成黄脓痰。


白色的粘痰是表示呼吸道有轻微的炎症,常是感冒的患者。
因为这种痰里存在大量病毒以及巨噬白细胞(一种免疫细胞)的尸体。在电子显微镜下,会发现许多白细胞和各种类型的感冒病毒。
治疗白色粘痰是最常见,也最容易治疗。

☆
黄色或绿色的浓痰
☆
体内有化脓性炎症,就是重呼吸道感染,气管炎或者支气管炎等。这与肺炎球菌引起的大叶肺炎区别很大,是化脓性细菌(常见的有葡萄球菌、链球
菌、绿脓杆菌等)感染人体而出现化脓,脓液为死亡的白细胞、坏死组织。
一般情况下,吸烟、感染和大气污染等环境下很容易引起慢性支气管炎症,发炎就会带来肿胀。
呼气时支气管炎患者的气管会变得非常狭窄(远比常人狭窄),空气就会滞留在肺部排不出去。
肺泡内压不断增高,导致肺泡过度膨胀或破裂。就像一个充了大量气体的气球,过度膨胀爆裂一样。
肺部就会含有少量的血红细胞,而由于肺泡内空气的存在,痰液中本身存在大量的气体,所以咳出来的痰就会呈粉红色泡沫状。肺气肿患者往往伴随有呼吸衰竭。
儒兰金线莲抗“炎”效果佳
金线莲富含活性极强的多糖、8种以上黄酮、牛磺酸、氨基酸、强心甙,及其他微量元素等等。其中多糖、黄酮类化合物,具有非常强的抗炎作用,多糖、黄酮还具有清除自由基功能。
北京大学基础医学院免疫学系教授王月丹:讲解金线莲的特殊功效
【儒兰金线莲相关案例】
感冒
咳嗽


小孩咳嗽


慢性支气管炎